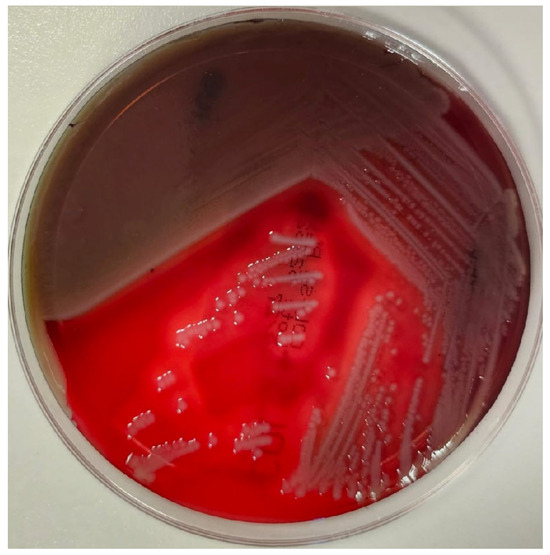

Abstract
Aeromonas is a genus of Gram-negative, facultatively anaerobic bacteria commonly found in aquatic environments and increasingly recognized as opportunistic pathogens. Among them, Aeromonas dhakensis stands out for its high virulence and antimicrobial resistance, but it is often misidentified due to its phenotypic similarity with A. hydrophila and A. caviae. In this study, a microorganism was isolated from the peritoneal fluid of a patient with signs of intra-abdominal infection. MALDI-TOF MS initially suggested A. hydrophila or A. caviae, but the identification was confirmed with high confidence only after further molecular analyses and the use of genome-based tools, which identified the organism as A. dhakensis. This was further supported by phylogenomic and ANI analysis. Resistome analysis revealed intrinsic resistance genes, including a chromosomal class C β-lactamase and an imiH-type carbapenemase, consistent with the observed carbapenem resistance. No plasmid-mediated carbapenemases were found. These findings underscore the limitations of MALDI-TOF in identifying Aeromonas species in certain cases and highlight the value of genomic approaches for accurate species determination and resistance profiling, especially for isolates from sterile body fluids.
1. Background
The genus Aeromonas refers to Gram-negative rods belonging to the order Aeromonadales, family Aeromonadaceae, and comprises several species with a global distribution, widely recognized for their presence in freshwater and brackish environments [1]. This genus includes more than 30 described species, among which Aeromonas hydrophila, Aeromonas veronii, and Aeromonas caviae have emerged as clinically significant pathogens in human infections, causing a wide range of diseases, from acute gastroenteritis to skin and soft tissue infections or cholangitis and abdominal sepsis in more severe cases. Although relatively infrequent, this ability, coupled with their intrinsic resistance to antibiotics including piperacillin and third-generation cephalosporins, underscores the need for a deeper understanding of their biology and epidemiology [1].
The natural habitats of Aeromonas include surface waters, potable water distribution systems, and aquatic food products such as fish and shellfish, facilitating their contact with humans. Aeromonas spp. have also been isolated from clinical environments, including wounds, the urinary tract, and, most notably, the gastrointestinal tract. In the latter case, gastrointestinal infections associated with Aeromonas are typically self-limiting, characterized by watery diarrhea [2]. However, in immunocompromised and aged individuals, these bacteria can trigger severe invasive infections such as cholangitis, abdominal abscesses, and sepsis [3,4]. Transmission can occur through the ingestion of contaminated water or food or the direct exposure of wounds to infected water. Notably, Aeromonas has been implicated in outbreaks following natural disasters, where flooding and the disruption of water sanitation systems increase the risks of exposure and infection [5].
The antimicrobial susceptibility profile of Aeromonas is complex due to the presence of chromosomal beta-lactamases, particularly various alleles of the TRU and MOX families, as class C enzymes, conferring their intrinsic resistance to most penicillins and cephalosporins. Certain species, such as A. hydrophila and the closely related and recently described Aeromonas dhakensis, can harbor chromosomal carbapenemases of the ImiH family, hindering effective antimicrobial selection even further [6]. Nevertheless, antibiotics such as fluoroquinolones, aminoglycosides, and fourth-generation cephalosporins have demonstrated effective activity against these bacteria and are the treatments of choice for severe infections. However, acquired resistance through plasmids or integrons has also been reported, highlighting the importance of rational antibiotic use to prevent the dissemination of resistant strains. The coexistence of these intrinsic carbapenemases with other acquired resistance mechanisms, such as efflux pumps and porin mutations, exacerbates the problem and underscores the need for continuous follow-up [7].
The precise identification of species within the Aeromonas genus presents a significant challenge due to the high genetic, proteomic, and phenotypic similarity among species. While molecular techniques such as PCR and 16S rRNA gene sequencing are valuable tools, mass spectrometry systems like (MALDI-TOF MS, MALDI BiotyperTM, Bruker®, Bremen, Germany) have shown limitations in differentiating closely related species. Specifically, distinction between A. hydrophila and A. dhakensis is particularly challenging, as they share a similar proteomic profile, which complicates their identification by this method, and it is not covered in commercial databases for in vitro diagnostics. This can lead to diagnostic errors that affect both epidemiological understanding and the implementation of targeted therapies [8].
Recent studies have highlighted that many infections previously attributed to A. hydrophila are actually caused by A. dhakensis. The latter, originally identified as a subgroup of A. hydrophila, has been recognized as a distinct species with greater pathogenicity in humans. Advanced molecular methods, including multilocus sequence typing (MLST) and the analysis of specific genes such as rpoD and gyrB, have proven to be useful tools in differentiating these two species. Furthermore, whole-genome sequencing bioinformatics tools have correctly identified both species and also revealed significant differences in genes associated with virulence factors and antimicrobial resistance between them [9,10].
This study aims to molecularly characterize an isolate of A. dhakensis initially misidentified as A. caviae or A. hydrophila, emphasizing its antimicrobial resistance profile and the implications for diagnosis and treatment.
2. Materials and Methods
2.1. Clinical and Microbiological Procedures
Clinical and microbiological data were extracted from the electronic medical records and the laboratory information system (LIS), with the patient’s consent.
The microorganism was isolated from a peritoneal fluid sample obtained during surgical intervention. The sample was processed following the standardized protocols of the Microbiology Laboratory at Miguel Servet University Hospital, which included procedures for ascitic/peritoneal fluid processing: Gram staining, inoculation of various culture media, and inoculation into an enrichment medium (BD BACTECTM Plus anaerobic medium, Becton Dickinson®, Franklin Lakes, NJ, USA). The culture media used were as follows: Columbia Agar with sheep blood plus (Thermo ScientificTM®, Walthman, MA, USA), Chocolate Agar (Becton Dickinson®, Franklin Lakes, NJ, USA), MacConkey Agar (Oxoid®, Waltham, MA, USA), Schaedler Agar (Becton Dickinson®, Franklin Lakes, NJ, USA), and Sabouraud Gentamicin Chloramphenicol Agar (SGC2, bioMérieux®, Marcy-l’Étoile, France).
Microbial identification was performed using matrix-assisted laser desorption/ionization time-of-flight mass spectrometry (MALDI-TOF MS, MALDI BiotyperTM, Bruker®, Bremen, Germany), following the manufacturer’s instructions [11]. Prior to genomic DNA extraction, the colony was subcultured on blood agar and incubated in an aerobic atmosphere for 24 h to ensure purity and maximize the biomass yield.
Antimicrobial susceptibility testing was performed using the MicroScanTM NEG MIC 57 panel (Catalog No. C58012; Beckman Coulter®, Brea, CA, USA). To investigate potential carbapenemase production, the NG-Test® CARBA-5 assay (NG-Biotech®, Guipry, France) and the eazyplexTM SuperBug Expert kit (Amplex Diagnostic®, Gars am Inn, Germany) were employed to detect the most prevalent plasmid-mediated carbapenemases. Additionally, the carbapenem inactivation method (CIM) was performed, following standard procedures.
2.2. Genomic Sequencing Analysis
Genomic DNA was extracted from a pure bacterial culture using bead-based nucleic acid extraction on the MagCore System (RBC Bioscience®, New Taipei City, Taiwan). The DNA yield was quantified using a Qubit fluorometer (ThermoFisher Scientific®, Walthman, MA, USA), and library preparation was performed using the Nextera XT kit (Illumina®, San Diego, CA, USA). Sequencing was performed on a MiSeq platformTM (Illumina®, San Diego, CA, USA) using a 150 bp paired-end protocol (300 cycles). Raw read quality was assessed and filtered using the fastQC [12] v0.12.1 and trimmomatic [13] v0.39 software with the following parameters: LEADING = 3, TRAILING = 5, SLIDINGWINDOW = 4:25, and MINLEN = 50. Genome assembly was performed using the unicycler [14] v0.5.0 software, and no contamination was detected with the gunc [15] v1.0.5 software. The quality of the assembly was assessed using quast [16] v5.2.0. The draft genome was annotated using Prokka [17] v1.14.6.
A multi-step approach for species identification was carried out using the annotation and draft genome files. First, with the annotation file, the 16S RNA, rpoD (RNA polymerase sigma factor RpoD), and gyrB (DNA gyrase subunit B) gene sequences were compared to standard databases (core_nt) using BLAST. Genome-based identification was then attempted using gambit [18] v1, mash [19] v2.1, the PubMLST [20] species identification service, the fIDBAC [21] species identification service, and the Type Strain Genome Server (TYGS) [22].
A dendrogram based on the average nucleotide identity (ANI) was constructed using dRep [23] v3.4.5, comparing all Aeromonas genomes present in GenBank with isolate Aeromonas_1268465, considering ANI ≥ 95% as a species threshold.
A maximum-likelihood phylogeny based on single-nucleotide polymorphisms was constructed using snippy [24] v.4.6.0 and iqtree [25] v.2.3.6, including 1000 ultrafast bootstraps. The Aeromonas dhakensis BC04 genome was selected as the reference genome, and Plesiomonas shigelloides 7A was used as an outgroup. Gubbins [26] v3.4 was used to handle recombination events. The final tree was visualized in iTOL [27] v.7.0. A heatmap comparing the average nucleotide identities and phylogenetic relationships of 15 related Aeromonas spp. species reference genomes was constructed using the ANIclustermap [28] v.1.4.0 tool (Supplementary Table S1).
2.3. Resistome Characterization
Resistome analysis was achieved using RGI [29] v6.0.3 (CARD v.3.2.9 database) and abricate [30] v1.0.1, which uses its own database. In addition, multiple sequence alignment was performed using Clustal Omega [31] v1.2.4 to determine the percentages of identity of the resistance genes.
Plasmid reconstruction was performed using MOB-Recon [32] v3.1.9.
3. Results
3.1. Clinical Case and Microbiological Findings
A 77-year-old male presented to the emergency department with a 24 h history of abdominal pain, initially localized to the hypogastric region and later becoming generalized throughout the abdomen, accompanied by nausea. The patient required urgent surgical intervention, with partial intestinal resection due to the identification of an intestinal perforation secondary to an infiltrative lesion, subsequently diagnosed as lymphoma, with associated purulent peritonitis. During the procedure, a sample of purulent peritoneal fluid was collected for microbiological analysis. The sample volume was 4 mL, and it had a purulent macroscopic appearance. Gram staining revealed abundant polymorphonuclear leukocytes (>25 PMN/field), Gram-positive cocci in chains, and Gram-negative bacilli. After 24 h incubation on Columbia Agar, greyish colonies with a shiny appearance exhibiting β-hemolysis were observed (Figure 1).
Figure 1.
Aeromonas dhakensis (Aeromonas_1268465) colony.
These colonies—the focus of this report—were oxidase-positive (Oxidase Test Stick, LIOFILCHEMTM®, Roseto degli Abruzzi TE, Italia). Two other colony types were also isolated, identified as Escherichia coli and Citrobacter freundii by MALDI-TOF MS. Additionally, Candida albicans was isolated on SGC2. The same microorganisms described previously were isolated in the enrichment medium.
Initially, the microorganism of primary interest in this study was identified by MALDI-TOF MS, resulting in the following results: Aeromonas caviae with a score of 2.22, Aeromonas hydrophila with a score of 2.16, Aeromonas jandaei with a score of 2.08, Aeromonas caviae with a value of 2.05, and Aeromonas hydrophila subsp. hydrophila with a value of 2.05.
The microorganism exhibited resistance to the following antibiotics, with the indicated MICs (mg/L), according to CLSI interpretation [33]: Imipenem (>4) and Meropenem (>8). It demonstrated susceptibility to Cefotaxime (≤1), Cefepime (≤1), Ceftazidime (≤1), Aztreonam (≤1), Amikacin (≤8), Ciprofloxacin (≤0.06), Levofloxacin (≤0.5), and Trimethoprim/Sulfamethoxazole (≤2/38).
Susceptibility testing ruled out the presence of plasmid-mediated carbapenemases, including the IMP, IMI, GES, and GIM families. However, the carbapenem inactivation method (CIM) test with meropenem yielded a positive result, indicating carbapenemase activity. Based on these findings, A. caviae may be an incorrect identification, as this species is not typically associated with carbapenem resistance. Consequently, the MALDI-TOF MS identification was repeated, and the results obtained were as follows (Table 1).

Table 1.
MALDI-TOF MS identification results (second determination).
Carbapenemase production in A. hydrophila has been reported. Both initial identification and repeated analysis using MALDI-TOF mass spectrometry alternated between A. hydrophila and A. caviae. Based on these findings, the strain was studied by whole-genome sequencing, following the procedure described in the Section 2.
3.2. Genomic Confirmation of Aeromonas dhakensis
The average sequencing depth was 40×. Assembly quality metrics revealed 31 contigs, with the longest contig having 1,097,368 base pairs, an N50 value of 584,578, and a L50 of 3. The draft genome size was 4.6 Mb and it contained 4263 CDS, 6 rRNA, 102 tRNA, and 1 tmRNA.
A preliminary analysis based on 16S RNA gene BLAST v2.16.0 revealed that isolate Aeromonas_1268465 could correspond to Aeromonas dhakensis, Aeromonas caviae, or Aeromonas enteropelogenes, all with 100% identity. Further mapping of the rpoD and gyrB genes favored Aeromonas dhakensis, presenting 99.95% and 99.17% identity against Aeromonas dhakensis BC04 and Aeromonas dhakensis ADK624, respectively. Gambit and mash revealed that the isolate corresponded to Aeromonas spp. and Aeromonas hydrophila, respectively. In contrast, the PubMLST, fiDBAC, and TYGS tools identified the isolate as Aeromonas dhakensis.
Given the ambiguity of some results for species assignment, a general genomic relatedness analysis was performed. The ANI-based dendrogram also presented our isolate as Aeromonas dhakensis, with 97.28% nucleotide identity to Aeromonas dhakensis BC04. In the phylogenetic analysis, isolate Aeromonas_1268465 formed a monophyletic clade with Aeromonas dhakensis (Figure 2). The heatmap revealed that the isolate fit into the Aeromonas dhakensis cluster (Figure 3) (Supplementary Table S2).

Figure 2.
Maximum-likelihood phylogeny based on core-genome single-nucleotide polymorphisms (SNPs).

Figure 3.
Average nucleotide identity (ANI) heatmap of selected Aeromonas genomes.
The combined results provided sufficient evidence to identify isolate Aeromonas_1268465 as Aeromonas dhakensis.
3.3. Antimicrobial Resistance Profile
The resistance study revealed the presence of OXA-726, TRU-1, and imiH using the RGI tool, as well as OXA-724 and imiH7 using Abricate. These are two different OXA-type enzymes (OXA-726 and OXA-724), each detected by a different tool. However, alignment determined that there was no strong evidence for the presence of these resistance genes due to their low percentage identities: 95.97% for OXA-726, 95.47% for OXA-724, 92.81% for imiH, and 92.16% for imiH7.
Following a rigorous examination of the available data, it is concluded that the isolate Aeromonas_1268465 can be identified as Aeromonas dhakensis, which is known to carry the imiH gene. This gene has been shown to confer resistance to carbapenems.
In addition to plasmid reconstruction with MOB-Recon, which did not detect any plasmids, we also screened the genome for other mobile genetic elements, such as insertion sequences and integrative elements, using the same tool. No insertion sequences, integrative conjugative elements, or other mobilization-associated elements were identified in the draft genome. Therefore, no evidence of genomic elements indicative of mobilization was found.
4. Discussion
Peritonitis caused by Aeromonas spp. is an uncommon condition that typically occurs in patients with underlying pathologies, such liver cirrhosis, or those undergoing peritoneal dialysis. These microorganisms, commonly associated with gastrointestinal infections, can cause severe extraintestinal infections in immunocompromised individuals. In a study of 35 Aeromonas cases, 57% were extraintestinal biliary tract infections, with secondary bacteremia being the most frequent. Additionally, 63% of the patients had comorbidities, with neoplasms and diabetes mellitus being the most common [34]. Another study reported 38 cases of extraintestinal infections caused by Aeromonas (18 abdominal infections, 11 skin and soft tissue infections, 3 urinary tract infections, 3 respiratory tract infections, and 3 cases of bacteremia with no primary focus), highlighting that 76.3% of the patients had predisposing conditions like neoplasms, liver cirrhosis, and diabetes mellitus [35].
Regarding severity and clinical implications, it is important to note that Aeromonas peritonitis can be associated with bacteremia, increasing the severity of the clinical presentation. In patients with liver cirrhosis, spontaneous bacterial peritonitis caused by A. hydrophila has been reported in isolated cases, being likely related to the high mortality rate [36]. Additionally, Aeromonas intra-abdominal infections are often polymicrobial, as in this case, making treatment challenging and potentially worsening prognosis [35].
The treatment of Aeromonas infections should be based on the antimicrobial susceptibility of the isolate. In severe infections such as peritonitis, empirical treatment with carbapenems or piperacillin/tazobactam is recommended, with subsequent adjustment based on the antibiogram [34].
In our case, A. dhakensis was isolated, which, in addition to the TRU β-lactamase typical of the Aeromonas genus—conferring the ability to hydrolyze penicillins and broad-spectrum cephalosporins [37]—also exhibited OXA-726 and ImiH carbapenemases, with the latter being responsible for the carbapenem resistance [38] observed in our isolate.
The ImiH gene is a type of metallo-β-lactamase (Ambler class B) that selectively hydrolyzes carbapenems but no other β-lactams. It is chromosomally encoded and intrinsically present in the genomes of certain species, such as A. bestiarum, A. hydrophila, A. veronii biovar sobria, A. jandaei, and A. dhakensis, but has not been identified in A. caviae, A. trota, or A. schubertii [39]. Its expression is inducible, meaning that, while present in the genome, its activation depends on environmental factors and internal regulatory mechanisms [38,40].
The β-lactamase OXA-726 belongs to Ambler class D, conferring resistance to penicillins and potentially to some cephalosporins. Although its activity is generally lower compared to metallo-β-lactamases, its presence can contribute to high levels of carbapenem resistance [41]. The literature contains only one reported case of OXA-726 detection in A. dhakensis, isolated from an edible snail, which underscores the uniqueness and clinical relevance of our isolate [42], highlighting the remarkable characteristics of this case. Unlike ImiH, blaOXA-726 can be either chromosomal or plasmid-borne, facilitating its dissemination to other bacteria.
Thus, the expression of these enzymes in species like our isolate confers intrinsic resistance to carbapenems and first-line drugs such as piperacillin/tazobactam, used in severe infections, reducing the available therapeutic options for these patients. Identifying these enzymes is crucial in selecting appropriate treatments, preventing the spread of resistant strains, and improving infection control in clinical and environmental settings.
Species identification was achieved through whole-genome sequencing, a more precise and robust technique than conventional methods, allowing the analysis of key genes such as gyrB, rpoD, and 16S rRNA; it also allows for the detection of virulence and resistance genes such as ImiH and blaOXA-726. The use of the MALDI-TOF system did not allow for correct identification due to two main reasons. First, A. dhakensis is not included in its database. Second, A. caviae, A. hydrophila, and A. dhakensis exhibit highly similar protein profiles due to their belonging to the same genus, making differentiation through this technique particularly challenging. In fact, the system itself generates an alert indicating this issue. For these reasons, although sequencing is a more labor-intensive and time-consuming technique, it remains the most reliable option for the accurate identification of species within this complex.
Accurately identifying Aeromonas spp. involved in severe infections is essential for optimal antibiotic selection and in understanding resistance profiles, which is critical both for clinical management and epidemiological surveillance. In this context, the inclusion of A. dhakensis in MALDI-TOF MS databases, whether at the manufacturer or local level, is particularly relevant, as several studies suggest that A. dhakensis possesses significant pathogenic potential in humans. In our setting, A. dhakensis has been incorporated into the local MALDI-TOF MS database to improve species-level resolution [43,44].
Furthermore, previous isolates identified as A. hydrophila may actually be A. dhakensis, highlighting the need for a rapid and precise identification method to distinguish it from other species. However, refining the MALDI-TOF database would be necessary to minimize identification errors.
The clinical course was favorable after five days of treatment. The patient is currently under follow-up by the hematology service due to an underlying lymphoproliferative syndrome diagnosed during this episode.
From a clinical perspective, the utility of precise species identification in cases involving Aeromonas spp. must be weighed against the practicality and resource constraints of routine diagnostics. While MALDI-TOF MS is a powerful tool that reliably identifies Aeromonas at the genus level, it often lacks a sufficient resolution to distinguish closely related species such as A. hydrophila, A. caviae, and A. dhakensis. In most clinical scenarios, therapeutic decisions are guided primarily by the antimicrobial susceptibility profile of the isolate, regardless of the exact species. However, accurate species identification becomes particularly relevant in severe infections or in settings where emerging pathogens such as A. dhakensis, with distinct virulence traits and intrinsic resistance mechanisms, are implicated. While it may not be feasible to apply complex molecular methods routinely, their targeted use in cases with unusual resistance patterns, treatment failure, or severe infections could improve clinical outcomes and enhance epidemiological surveillance. Thus, the integration of high-resolution identification tools should be considered selectively, in conjunction with phenotypic susceptibility testing, to support both individualized patient care and public health monitoring.
An additional consideration in the challenge of identifying A. dhakensis is the potential value of emerging culture-based strategies such as culturomics. This approach, which combines a wide variety of culture conditions with rapid identification methods like MALDI-TOF MS and 16S rRNA sequencing, has proven highly effective in isolating bacteria that are difficult to grow under conventional protocols [45]. Through culturomics, hundreds of previously uncultured bacterial species have been recovered, and many of these have expanded our understanding of clinically relevant microbiota. By incorporating newly isolated strains into reference libraries, culturomics also enhances the discriminatory power of MALDI-TOF MS, which is particularly important when working with genera like Aeromonas that contain closely related species often misidentified due to overlapping proteomic profiles [46].
In the case of A. dhakensis, which is frequently misclassified as A. hydrophila or A. caviae due to the absence of species-specific reference spectra in many MALDI-TOF systems [8], culturomics represents a valuable complementary tool. It allows not only for the isolation of less represented or novel strains but also supports the expansion of taxonomic databases and facilitates follow-up genomic analyses for precise species identification. While culturomics was not employed in the present study, future applications of this methodology in the diagnostic setting could help to resolve ambiguous identifications like those encountered here and improve clinical decision-making in infections involving Aeromonas species.
Given the well-documented difficulty in accurately identifying A. dhakensis using conventional biochemical and proteomic methods, it is important to acknowledge that some data reported in the literature may reflect misidentified isolates. Historically, strains of A. dhakensis have often been classified as A. hydrophila or A. caviae, particularly in studies that relied on phenotypic or limited molecular approaches. This raises concerns about the reliability of earlier reports, especially those that did not incorporate the sequencing of discriminatory genes (e.g., gyrB, rpoD) or whole-genome-based identification tools. In light of this, a critical review of the literature is warranted, prioritizing studies that have applied high-resolution molecular or genomic methods for species-level identification. Such an approach would help to distinguish truly reliable data from potentially misassigned findings and improve our understanding of the epidemiology, resistance patterns, and clinical impacts of A. dhakensis.
Comparative genomic analyses have revealed that Aeromonas species harbor a highly diverse resistome. A recent large-scale study analyzing approximately 400 aquaculture-derived genomes—including A. salmonicida, A. hydrophila, A. veronii, A. media, and A. sobria—identified over 100 antimicrobial resistance genes (ARGs), with common determinants such as sul1, tet(A), and tet(D) present in about 25% of strains across species, suggesting widespread but uneven ARG distribution [47]. Notably, A. salmonicida and A. media exhibited species-specific ARG profiles, highlighting possible patterns of lineage-specific gene acquisition. Similarly, in a focused genomic analysis of 35 A. hydrophila strains, nearly all genomes carried β-lactam resistance genes, including those associated with resistance to cephalosporins and carbapenems [48].
These findings are consistent with data from global genomic repositories. For example, the MicroBIGG-E database reports that over 90% of Aeromonas isolates from diseased fish carry ARGs conferring resistance to aminoglycosides, β-lactams, tetracyclines, and trimethoprim [47]. Broad-spectrum β-lactamase genes such as oxa, cphA, ampC, and blaCMY are especially prevalent across species [49]. Additionally, resistance to last-line antibiotics has been reported, including mcr-3 (colistin), which appears almost exclusively in Aeromonas, and blaNDM-1, a carbapenemase gene identified in aquatic isolates of the genus [47]. Together, these comparative studies emphasize the global spread and species-specific dynamics of the Aeromonas resistome, underscoring the importance of integrating large-scale genomic surveillance to better understand antimicrobial resistance evolution in this genus.
5. Conclusions
In summary, the Aeromonas genus encompasses species of clinical and environmental relevance. The accurate differentiation of A. hydrophila and A. dhakensis is crucial in understanding their epidemiology and guiding therapeutic strategies. Investment in the development of new diagnostic tools capable of overcoming the current limitations, such as those of MALDI-TOF, and strategies to mitigate the spread of antimicrobial resistance are also necessary. Moreover, resistance mediated by intrinsic carbapenemases highlights the need for continuous surveillance and the development of new diagnostic and therapeutic approaches, emphasizing the importance of a multidisciplinary approach to address the challenges posed by these bacteria in global public health.
Supplementary Materials
The following supporting information can be downloaded at: https://www.mdpi.com/article/10.3390/amh70030034/s1.
Author Contributions
Conceptualization, D.B.-A.; methodology, D.B.-A. and A.T.-B.; software, D.B.-A.; validation, A.M.M.-B., J.M.G.-L. and A.I.L.-C.; formal analysis, D.B.-A.; investigation, D.B.-A., A.T.-B., N.B.-N. and S.S.-S.; resources, A.R.-L.; data curation, D.B.-A.; writing—original draft preparation, D.B.-A., A.T.-B., N.B.-N. and S.S.-S.; writing—review and editing D.B.-A., A.T.-B., N.B.-N., S.S.-S. and J.M.G.-L.; visualization, D.B.-A. and A.T.-B.; supervision, J.M.G.-L.; project administration, D.B.-A.; funding acquisition, A.R.-L. All authors have read and agreed to the published version of the manuscript.
Funding
This research received no external funding.
Institutional Review Board Statement
This study is part of a larger project approved by the Ethics Committee “Comité de Ética de la Investigación de la Comunidad Autónoma de Aragón (CEICA)” under protocol code PI24/155, approved on 17 April 2024.
Informed Consent Statement
The project received exemption from the requirement for informed consent (CI), for this specific case involving a single isolate, informed consent was obtained. All procedures were conducted in accordance with the ethical standards of the institutional research committee and with the Declaration of Helsinki.
Data Availability Statement
The genomes were submitted to GenBank on 05 June 2025 under BioSample ID SAMN48761348. The OXA-726 resistance gene was submitted to GenBank on 25 June 2025 under accession ID PV844849, the imiH resistance gene under accession ID PV844850, and the TRU-1 gene under accession ID PV844851.
Acknowledgments
During the preparation of this work, the authors used ChatGPT 4.0 and Google AI Studio 2.5 Pro in order to check spelling and grammar. After using this tool, the authors reviewed and edited the content as needed and take full responsibility for the content of the publication.
Conflicts of Interest
The authors declare no conflicts of interest.
References
- Fernández-Bravo, A.; Figueras, M.J. An Update on the Genus Aeromonas: Taxonomy, Epidemiology, and Pathogenicity. Microorganisms 2020, 8, 129. [Google Scholar] [CrossRef] [PubMed] [PubMed Central]
- Juan, H.J.; Tang, R.B.; Wu, T.C.; Yu, K.W. Isolation of Aeromonas hydrophila in children with diarrhea. J. Microbiol. Immunol. Infect. 2000, 33, 115–117. [Google Scholar] [PubMed]
- Minnaganti, V.R.; Patel, P.J.; Iancu, D.; Schoch, P.E.; Cunha, B.A. Necrotizing fasciitis caused by Aeromonas hydrophila. Heart Lung 2000, 29, 306–308. [Google Scholar] [CrossRef] [PubMed]
- Jiang, L.; Zhao, Q.; Li, D.; Gao, J.; Zhang, X.; Shu, Q.; Han, X. Fulminant fatal pneumonia and bacteremia due to Aeromonas dhakensis in an immunocompetent man: A case report and literature review. Front. Cell. Infect. Microbiol. 2024, 14, 1359422. [Google Scholar] [CrossRef] [PubMed] [PubMed Central]
- Carusi, J.; Kabuki, D.Y.; de Seixas Pereira, P.M.; Cabral, L. Aeromonas spp. in drinking water and food: Occurrence, virulence potential and antimicrobial resistance. Food Res. Int. 2024, 175, 113710. [Google Scholar] [CrossRef] [PubMed]
- Chen, X.; Lu, M.; Wang, Y.; Zhang, H.; Jia, X.; Jia, P.; Yang, W.; Chen, J.; Song, G.; Zhang, J.; et al. Emergence and clonal expansion of Aeromonas hydrophila ST1172 that simultaneously produces MOX-13 and OXA-724. Antimicrob. Resist. Infect. Control 2024, 13, 28. [Google Scholar] [CrossRef] [PubMed] [PubMed Central]
- Hilt, E.E.; Fitzwater, S.P.; Ward, K.; de St Maurice, A.; Chandrasekaran, S.; Garner, O.B.; Yang, S. Carbapenem Resistant Aeromonas hydrophila Carrying blaimiH7 Isolated From Two Solid Organ Transplant Patients. Front. Cell. Infect. Microbiol. 2020, 10, 563482. [Google Scholar] [CrossRef] [PubMed] [PubMed Central]
- Chen, P.L.; Lamy, B.; Ko, W.C. Aeromonas dhakensis, an Increasingly Recognized Human Pathogen. Front. Microbiol. 2016, 7, 793. [Google Scholar] [CrossRef] [PubMed] [PubMed Central]
- Chen, P.L.; Wu, C.J.; Chen, C.S.; Tsai, P.J.; Tang, H.J.; Ko, W.C. A comparative study of clinical Aeromonas dhakensis and Aeromonas hydrophila isolates in southern Taiwan: A. dhakensis is more predominant and virulent. Clin. Microbiol. Infect. 2014, 20, O428–O434. [Google Scholar] [CrossRef] [PubMed]
- Truong, N.H.M.; Nguyen, Q.; Voong, P.V.; Chau, V.; Nguyen, N.H.T.; Nguyen, T.H.M.; Vo, P.H.; Nguyen, L.T.; Ha, T.T.P.; Nguyen, L.P.H.; et al. Genomic characterization of Aeromonas spp. isolates from striped catfish with motile Aeromonas septicemia and human bloodstream infections in Vietnam. Microb. Genom. 2024, 10, 001248. [Google Scholar] [CrossRef] [PubMed] [PubMed Central]
- Bruker Daltonik, GmbH. MBT Compass User Manual; Revision C; Bruker Daltonik GmbH: Bremen, Germany, 2016. [Google Scholar]
- Babraham Bioinformatics—FastQC. A Quality Control Tool for High Throughput Sequence Data. Available online: https://www.bioinformatics.babraham.ac.uk/projects/fastqc/ (accessed on 25 March 2025).
- Bolger, A.M.; Lohse, M.; Usadel, B. Trimmomatic: A flexible trimmer for Illumina sequence data. Bioinformatics 2014, 30, 2114–2120. [Google Scholar] [CrossRef]
- Wick, R.R.; Judd, L.M.; Gorrie, C.L.; Holt, K.E. Unicycler: Resolving bacterial genome assemblies from short and long sequencing reads. PLoS Comput. Biol. 2017, 13, e1005595. [Google Scholar] [CrossRef] [PubMed]
- Orakov, A.; Fullam, A.; Coelho, L.P.; Khedkar, S.; Szklarczyk, D.; Mende, D.R.; Schmidt, T.S.B.; Bork, P. GUNC: Detection of chimerism and contamination in prokaryotic genomes. Genome Biol. 2021, 22, 178. [Google Scholar] [CrossRef] [PubMed]
- Gurevich, A.; Saveliev, V.; Vyahhi, N.; Tesler, G. QUAST: Quality assessment tool for genome assemblies. Bioinformatics 2013, 29, 1072–1075. [Google Scholar] [CrossRef] [PubMed]
- Seemann, T. Prokka: Rapid prokaryotic genome annotation. Bioinformatics 2014, 30, 2068–2069. [Google Scholar] [CrossRef]
- Lumpe, J.; Gumbleton, L.; Gorzalski, A.; Libuit, K.; Varghese, V.; Lloyd, T.; Tadros, F.; Arsimendi, T.; Wagner, E.; Stephens, C.; et al. GAMBIT (Genomic Approximation Method for Bacterial Identification and Tracking): A methodology to rapidly leverage whole genome sequencing of bacterial isolates for clinical identification. PLoS ONE 2023, 18, e0277575. [Google Scholar] [CrossRef]
- Ondov, B.D.; Treangen, T.J.; Melsted, P.; Mallonee, A.B.; Bergman, N.H.; Koren, S.; Phillippy, A.M. Mash: Fast genome and metagenome distance estimation using MinHash. Genome Biol. 2016, 17, 132. [Google Scholar] [CrossRef]
- PubMLST—Public Databases for Molecular Typing and Microbial Genome Diversity. Available online: https://pubmlst.org/ (accessed on 25 March 2025).
- Liang, Q.; Liu, C.; Xu, R.; Song, M.; Zhou, Z.; Li, H.; Dai, W.; Yang, M.; Yu, Y.; Chen, H. fIDBAC: A Platform for Fast Bacterial Genome Identification and Typing. Front. Microbiol. 2021, 12, 723577. [Google Scholar] [CrossRef]
- Meier-Kolthoff, J.P.; Göker, M. TYGS is an automated high-throughput platform for state-of-the-art genome-based taxonomy. Nat. Commun. 2019, 10, 2182. [Google Scholar] [CrossRef]
- Olm, M.R.; Brown, C.T.; Brooks, B.; Banfield, J.F. dRep: A tool for fast and accurate genomic comparisons that enables improved genome recovery from metagenomes through de-replication. ISME J. 2017, 11, 2864–2868. [Google Scholar] [CrossRef]
- Seemann, T. Tseemann/Snippy. (Original Work Published 2014). 2025. Available online: https://github.com/tseemann/snippy (accessed on 25 March 2025).
- Nguyen, L.-T.; Schmidt, H.A.; Von Haeseler, A.; Minh, B.Q. IQ-TREE: A Fast and Effective Stochastic Algorithm for Estimating Maximum-Likelihood Phylogenies. Mol. Biol. Evol. 2015, 32, 268–274. [Google Scholar] [CrossRef] [PubMed]
- Croucher, N.J.; Page, A.J.; Connor, T.R.; Delaney, A.J.; Keane, J.A.; Bentley, S.D.; Parkhill, J.; Harris, S.R. Rapid phylogenetic analysis of large samples of recombinant bacterial whole genome sequences using Gubbins. Nucleic Acids Res. 2015, 43, e15. [Google Scholar] [CrossRef] [PubMed]
- Letunic, I.; Bork, P. Interactive Tree of Life (iTOL) v6: Recent updates to the phylogenetic tree display and annotation tool. Nucleic Acids Res. 2024, 52, W78–W82. [Google Scholar] [CrossRef]
- Shimoyama, Y. ANIclustermap: A Tool for Drawing ANI Clustermap Between All-vs-All Microbial Genomes. (Original Work Published 2022). 2022. Available online: https://github.com/moshi4/ANIclustermap (accessed on 25 March 2025).
- GitHub—Arpcard/Rgi: Resistance Gene Identifier (RGI). Software to Predict Resistomes from Protein or Nucleotide Data, Including Metagenomics Data, Based on Homology and SNP Models. GitHub. Available online: https://github.com/arpcard/rgi (accessed on 25 March 2025).
- Seemann, T. Tseemann/Abricate. (Original Work Published 2014). 2025. Available online: https://github.com/tseemann/abricate (accessed on 25 March 2025).
- Sievers, F.; Higgins, D.G. Clustal omega. Curr. Protoc. Bioinform. 2014, 48, 3–13. [Google Scholar] [CrossRef]
- Robertson, J.; Bessonov, K.; Schonfeld, J.; Nash, J.H.E. Universal whole-sequence-based plasmid typing and its utility to prediction of host range and epidemiological surveillance. Microb. Genom. 2020, 6, e000435. [Google Scholar] [CrossRef]
- Clinical and Laboratory Standards Institute (CLSI). Clinical and Laboratory Standards Institute (CLSI). Methods for Antimicrobial Dilution and Disk Susceptibility Testing of Infrequently Isolated or Fastidious Bacteria. In Methods for Antimicrobial Dilution and Disk Susceptibility Testing of Infrequently Isolated or Fastidious Bacteria, 3rd ed; CLSI guideline M45: Wayne, PA, USA, 2016; Available online: www.clsi.org (accessed on 21 March 2025).
- Soto Peleteiro, A.; Gómez, J.; Sousa, A.; Rodríguez, A.; Pérez, M.; Martínez, L.; Argibay, A.; Nodar, A. Infección por Aeromonas: Revisión de 35 casos. In Proceedings of the XXXV Congreso Nacional de la Sociedad Española de Medicina Interna (SEMI), Murcia, Spain, 19–21 November 2014; Hospital Xeral de Vigo: Vigo, Spain. [Google Scholar]
- Tena, D.; González-Praetorius, A.; Gimeno, C.; Pérez-Pomata, M.T.; Bisquert, J. Infección extraintestinal por Aeromonas spp.: Revisión de 38 casos. Enferm. Infecc. Microbiol. Clin. 2007, 25, 235–241. [Google Scholar] [CrossRef]
- García-Irure, J.; Navascués, A.; Vivanco, M.; Rodrigo, A. Peritonitis bacteriana espontánea y bacteriemia por Aeromonas hydrophila. An. Sist. Sanit. Navar. 2008, 26, 429–431. [Google Scholar] [CrossRef]
- De Luca, F.; Giraud-Morin, C.; Rossolini, G.M.; Docquier, J.D.; Fosse, T. Genetic and biochemical characterization of TRU-1, the endogenous class C beta-lactamase from Aeromonas enteropelogenes. Antimicrob. Agents Chemother. 2010, 54, 1547–1554. [Google Scholar] [CrossRef] [PubMed] [PubMed Central]
- Segatore, B.; Massidda, O.; Satta, G.; Setacci, D.; Amicosante, G. High specificity of imiH-encoded metallo-beta-lactamase from Aeromonas hydrophila AE036 for carbapenems and its contribution to beta-lactam resistance. Antimicrob. Agents Chemother. 1993, 37, 1324–1328. [Google Scholar] [CrossRef] [PubMed] [PubMed Central]
- Rossolini, G.M.; Zanchi, A.; Chiesurin, A.; Amicosante, G.; Satta, G.; Guglielmetti, P. Distribution of imiH or related carbapenemase-encoding genes and production of carbapenemase activity in members of the genus Aeromonas. Antimicrob. Agents Chemother. 1995, 39, 346–349. [Google Scholar] [CrossRef] [PubMed] [PubMed Central]
- Massidda, O.; Rossolini, G.M.; Satta, G. The Aeromonas hydrophila imiH gene: Molecular heterogeneity among class B metallo-beta-lactamases. J. Bacteriol. 1991, 173, 4611–4617. [Google Scholar] [CrossRef] [PubMed]
- Vila, J.; Francesc, M. Lectura interpretada del antibiograma de bacilos gram negativos no fermentadores. Enferm. Infecc. Microbiol. Clin. 2010, 28, 726–736. [Google Scholar] [CrossRef] [PubMed]
- Okafor, A.C.; Ogbo, F.C.; Cabal Rosel, A.; Stöger, A.; Akharaiyi, F.C.; Prieto, B.; Allerberger, F.; Ruppitsch, W. Genome Sequence of OXA-726-Encoding Aeromonas dhakensis Igbk (Sequence Type 1171) from an Edible Snail Traded in Nigeria. Microbiol. Resour. Announc. 2022, 11, e0034322. [Google Scholar] [CrossRef] [PubMed] [PubMed Central]
- Elorza, A.; Rodríguez-Lago, I.; Martínez, P.; Hidalgo, A.; Aguirre, U.; Cabriada, J.L. Infección gastrointestinal por Aeromonas: Incidencia y su posible relación con la enfermedad inflamatoria intestinal. Gastroenterol. Y Hepatol. 2020, 43, 614–619. [Google Scholar] [CrossRef]
- Alonso Serena, M.; Franchi, A.; Asef, K.; Kunst, A.; De Aguilar, L.; Almuzara, M. Infecciones por Aeromonas spp. en pacientes internados en un hospital general de agudos. In Proceedings of the XVII Congreso SADI 2017, Mar del Plata, Argentina, 15–17 June 2017. [Google Scholar]
- Lagier, J.C.; Hugon, P.; Khelaifia, S.; Fournier, P.E.; La Scola, B.; Raoult, D. The Rebirth of Culture in Microbiology Through the Example of Culturomics to Study Human Gut Microbiota. [Internet]. Clin. Microbiol. Rev. 2015, 28, 237–264. [Google Scholar] [CrossRef]
- Dubourg, G.; Baron, S.; Cadoret, F.; Couderc, C.; Fournier, P.E.; Lagier, J.C.; Raoult, D. From Culturomics to Clinical Microbiology and Forward. Emerg. Infect. Dis. 2018, 24, 1683–1690. [Google Scholar] [CrossRef]
- Roh, H.; Kannimuthu, D. Comparative resistome analysis of Aeromonas species in aquaculture reveals antibiotic resistance patterns and phylogeographic distribution. Environ. Res. 2023, 239 Pt 2, 117273. [Google Scholar] [CrossRef]
- Guo, Y.; Zeng, C.; Ma, C.; Cai, H.; Jiang, X.; Zhai, S.; Xu, X.; Lin, M. Comparative genomics analysis of the multidrug-resistant Aeromonas hydrophila MX16A providing insights into antibiotic resistance genes. Front. Cell. Infect. Microbiol. 2022, 12, 1042350. [Google Scholar] [CrossRef]
- Fono-Tamo, E.U.K.; Kamika, I.; Dewar, J.B.; Lekota, K.E. Comparative Genomics Revealed a Potential Threat of Aeromonas rivipollensis G87 Strain and Its Antibiotic Resistance. Antibiotics 2023, 12, 131. [Google Scholar] [CrossRef]
Disclaimer/Publisher’s Note: The statements, opinions and data contained in all publications are solely those of the individual author(s) and contributor(s) and not of MDPI and/or the editor(s). MDPI and/or the editor(s) disclaim responsibility for any injury to people or property resulting from any ideas, methods, instructions or products referred to in the content. |
© 2025 by the authors. Published by MDPI on behalf of the Hellenic Society for Microbiology. Licensee MDPI, Basel, Switzerland. This article is an open access article distributed under the terms and conditions of the Creative Commons Attribution (CC BY) license (https://creativecommons.org/licenses/by/4.0/).